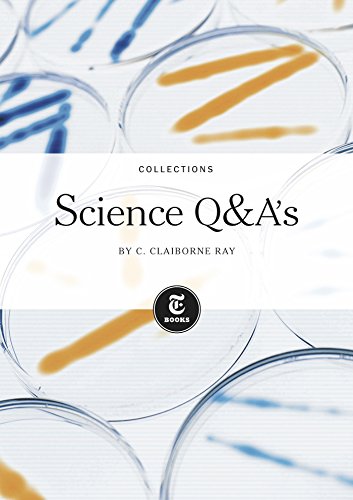
Science Q&A's

Science Q&A's Book PDF, ePub eBook

Science Q&A's.pdf
File Name: Science Q&A's.pdf
Size: 30.24 MB
Uploaded: 2017-02-14 04:11:4
File Name: Science Q&A's.pdf
Size: 30.24 MB
Uploaded: 2017-02-14 04:11:4